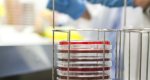
El Hospital de Dénia, centro experto en el manejo de la transfusión de sangre El Hospital de Dénia, centro experto en el manejo de la transfusión de sangre
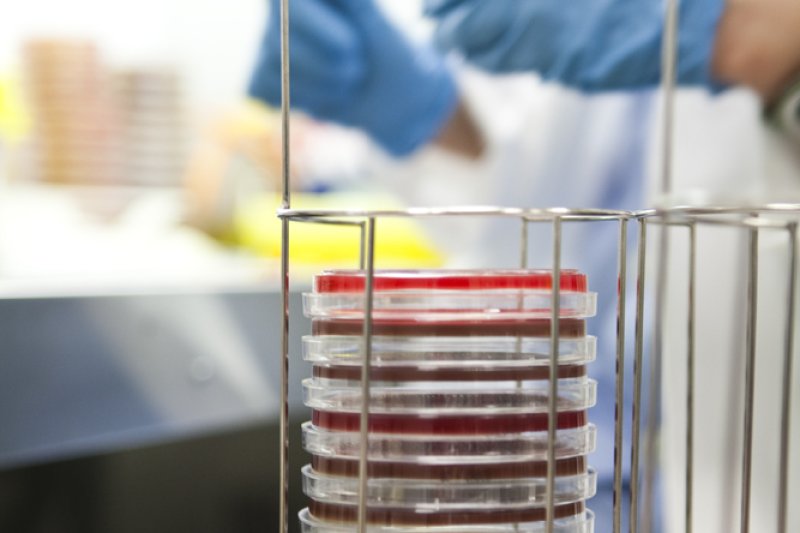
El Hospital de Dénia, centro experto en el manejo de la transfusión de sangre El Hospital de Dénia, centro experto en el manejo de la transfusión de sangre

L'Hospital de Dénia, centre expert en el maneig de la transfusió de sang
La disminució de les transfusions innecessàries millora el postoperatori i la seguretat del pacient
L'Hospital de Dénia és un centre expert en pràctiques de maneig de la transfusió de sang i se situa en posicions d'excel·lència en alguns procediments quirúrgics freqüents. Les últimes dades publicades per MAPBM, (Maturity Assessment in Patient Blood Management) situen al centre dianense a nivell expert en la taxa de transfusions en procediments quirúrgics, com la cirurgia de pròtesi de maluc i genoll, la cirurgia oncològica colorectal oberta i laparoscòpica i la histerectomia abdominal.
L'índex MAPBM és un model d'avaluació que permet identificar la variabilitat transfusional per procediments en les pràctiques clíniques que es realitzen en la transfusió, així com la utilització dels anomenats tres pilars PBM per a aconseguir millorar les taxes transfusionals. L'objectiu és ajudar els hospitals a adequar la seua pràctica clínica per a reduir les transfusions innecessàries o evitables i l'ús d'un recurs escàs i inestimable com és la sang.
L'Hospital de Dénia ja ha sigut guardonat en dues ocasions -2022 i 2018- pel seu índex de progressió en les bones pràctiques en el Maneig de la Sang del Pacient. Entre els 51 hospitals espanyols adherits actualment al projecte, hi ha centres de referència com l'Hospital Gregorio Marañón de Madrid, el Clínic o la Vall d’Hebron de Barcelona. En 2022 va ser, a més, finalista com a Millor Hospital Sense Cirurgia Cardíaca.
La transfusió de sang inadequada o evitable és una pràctica imprescindible i té una important repercussió en l'evolució clínica del pacient. Per aquesta raó, l'Organització Mundial de la Salut -OMS- promou des de 2010 el desenvolupament de programes multidisciplinaris, coneguts genèricament com Patient Blood Management amb l'objectiu que el pacient arribe a la cirurgia en les condicions idònies per a evitar la transfusió sanguínia inadequada.

-(1)jpg)














png)
